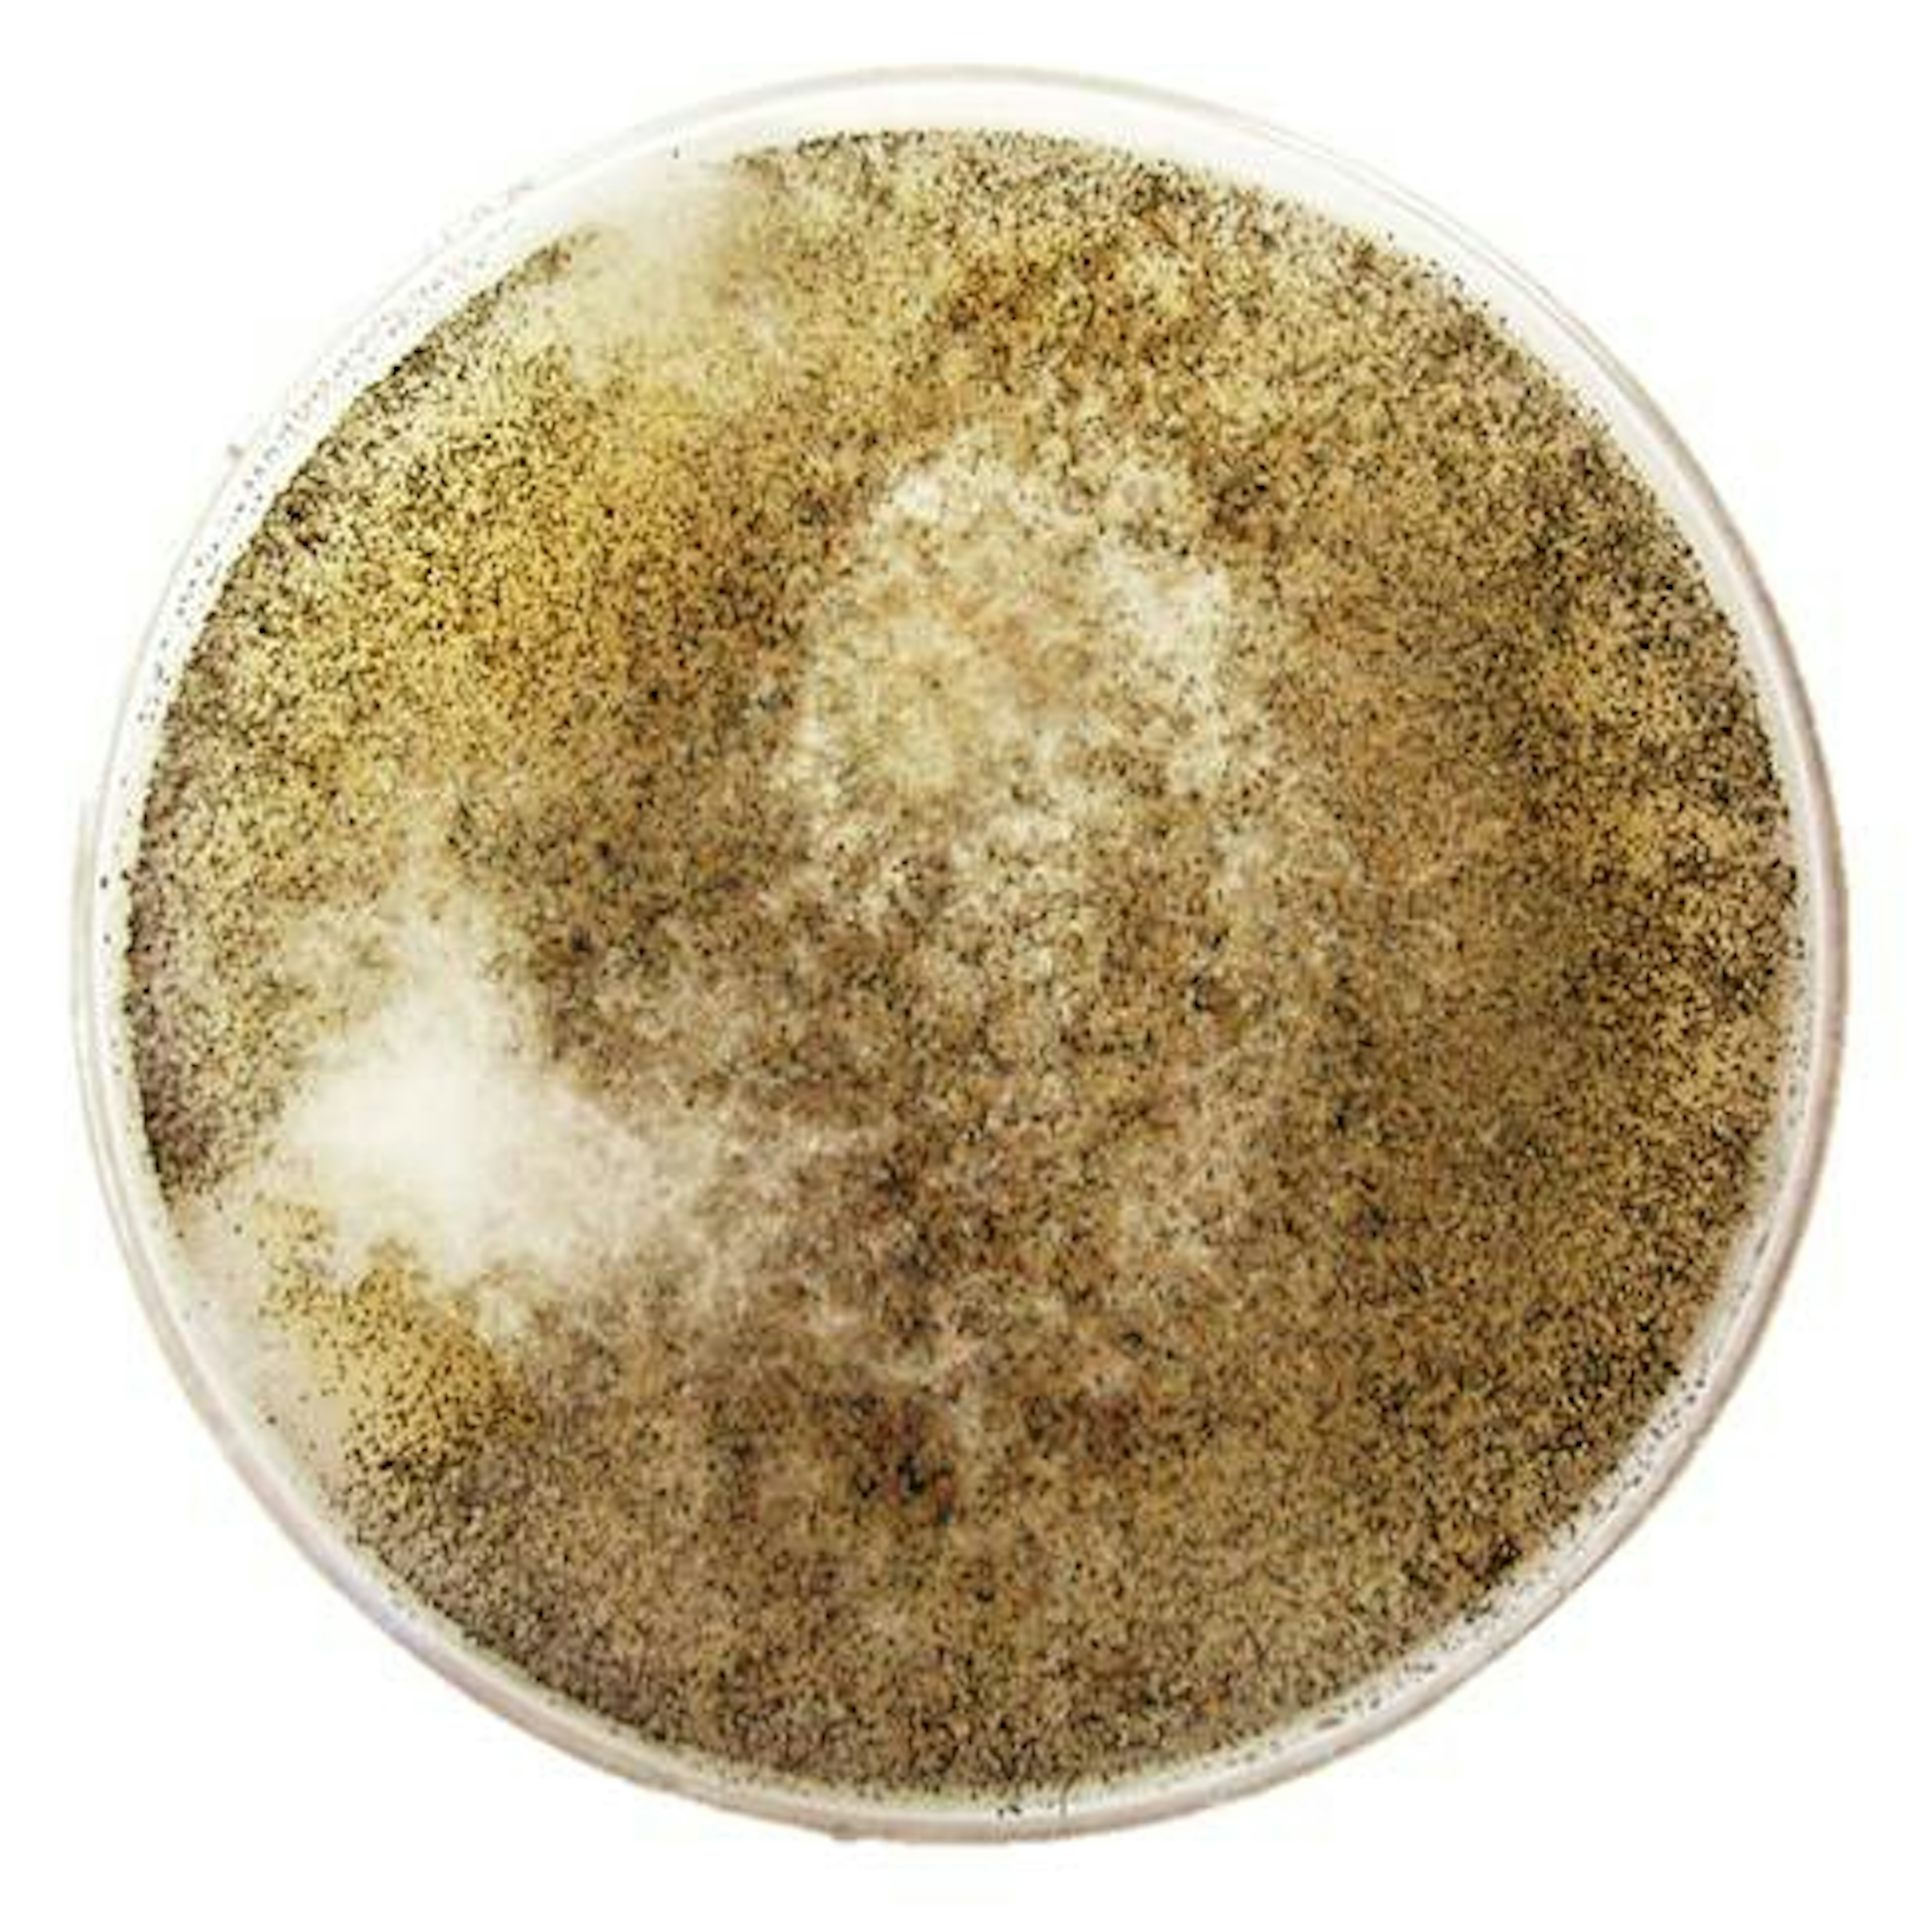

|
Kinshasa’s 400 markets are an essential part of life for the estimated 10 million Congolese who live in the capital. The markets are also a major source of revenue for a host of players, including high ranking officials. Kristof Titeca and Albert Malukisa Nkuku explain how their research has lifted the lid on how the city’s markets are run, in particular how networks of patronage ensure profits are siphoned off to well-connected individuals.
Different species use a variety of approaches to the all-important business of reproduction. Fungi can utilise one or more of six different sexual strategies; some don’t need a partner to procreate and can do it alone. Andi Wilson explains the risks this method poses - not to the fungi, but to tree plantations and even humans.
|

A vendor at the Sigida Market, in Kinshasa, Democratic Republic of Congo.
ReutersS/Robert Carrubba
Kristof Titeca, University of Antwerp; Albert Malukisa Nkuku, University of Antwerp
Graft is common in the way that markets in Kinshasa are run.
|
The sweet-smelling, fluffy white fungus, Huntiella moniliformis, engaging in sexual reproduction in the lab.
Author supplied
Andi Wilson, University of Pretoria
Understanding the sex lives of fungi can help in finding answers about disease control.
|
Business + Economy
|
-
Olorunjuwon Samuel, University of the Witwatersrand
Corporates are willing to embrace corporate social responsibility initiatives. But many fail due to cultural insensitivity and misplaced communication strategies.
|
|
Politics + Society
|
-
Robert Mattes, University of Cape Town
Former South African President Jacob Zuma's bad behaviour damaged his image and the ANC's.
|
|
From our international editions
|
-
Maria Ryan, University of Nottingham
Thanks to South Korea, there is a chance for peace with North Korea. Whether the Trump administration can take it is another matter.
-
Nicolas Geeraert, University of Essex
Psychological phenomena have long been thought of as universal. But it turns out scientists may have been blinded by their own culture.
-
William Hauk, University of South Carolina
President Trump slapped steep tariffs on steel imports, echoing protectionist measures taken by Bush in 2002.
|
|